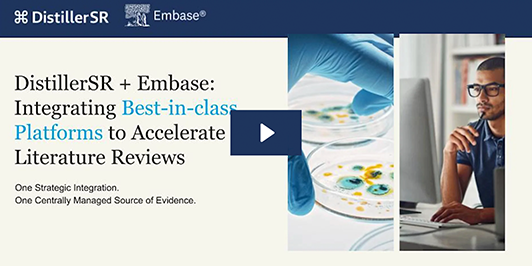
embase + distillersr webinar recording

ISPOR Europe 2025 Resources
Featured Resources

DistillerSR + Embase Integration
Integrating Best-in-class Platforms to Accelerate Literature Reviews

Webinar
DistillerSR Best Practices Webinar: Improve Research Efficiency and Reduce Costs with Agentic AI
Additional Resources

Purpose-built GenAI for Literature Reviews
Learn how reviewers can focus on high-value work, reduce fatigue, and meet the rising demand for faster, more accurate reviews.

Scientifically Validated AI
DistillerSR is a pioneer in the use of AI for literature reviews.

Webinar
Data Harmonization Driving Trusted Evidence Management Throughout the Product Life Cycle

Blog
NuVasive and Geistlich Pharma Share Best Practices for EU MDR State of the Art Submissions While Achieving More Efficient Literature Reviews with DistillerSR

Video
Automating Literature Reviews for Pharmacovigilance Animated Video

Recording
Pharmacovigilance Mistakes Are Not an Option: Literature Reviews and Pharmacovigilance

Blog
Xcenda, Maple Health Group and Curta discuss how automating literature reviews helps streamline HTAs submissions.

Abbott Diagnostics
DistillerSR Enabled the Abbott Diagnostics Team to Complete Literature Reviews 50% Faster

Medlior
With as many as 40,000 references per project, Medlior, used DistillerSR to more accurately and efficiently manage their literature reviews.

Maple Health Group
DistillerSR enabled Maple Health Group to improve efficiency and optimize resource allocation.
Webinar
Stay Ahead Of The Game: How To Conduct An Evidence-Based GVD Faster And Smarter To Improve Market Access
Webinar
Streamlining Health Technology Assessments (HTAs) by Automating Literature Reviews
Webinar
How Literature Review Automation and Efficient Processes Streamline RWE HEOR Studies
Webinar
Can Literature Review Automation Improve Healthcare Cost-Effectiveness Analysis and Budget Impact Modeling Outcomes?
Webinar
How Information Overload is Driving New Approaches for HEOR Systematic Literature Reviews
Webinar
Data Harmonization Driving Trusted Evidence Management Throughout the Product Life Cycle
Improve Cost-Effectiveness Analysis and Budget Impact Modeling Using Literature Review Automation Software
This business brief outlines a customized SLR solution for health economics and outcomes research.
Real-World Evidence: Using Systematic Literature Reviews for Evidence Synthesis…
A guide for researchers using systematic reviews for RWE study design or RWE literature synthesis.

Information Overload Drives New Approaches to Managing HEOR Literature Reviews
Apply automation and intelligent workflows to HEOR literature reviews to improve health decisions.
Streamlining Health Technology Assessments by Automating Literature Reviews
Automating some of the functions of a review can increase the efficiency and accuracy of HTAs.
Smart Automation of SLRs for GVDs: Faster Market Access for New Drugs
Automating aspects of the SLR can improve its accuracy and efficiency while supporting the development of a…
Enterprise Evidence Management for Trusted Healthcare Decision Making
Discover how an enterprise evidence management strategy can lead to product success and better patient outcomes.
Future-Proofing Evidence for Better Patient Outcomes
Product data, be it from preclinical development, bench testing, clinical studies, real-world evidence (RWE), or scientific literature reviews…

Purpose-built GenAI for Literature Reviews
Learn how reviewers can focus on high-value work, reduce fatigue, and meet the rising demand for faster, more accurate reviews.
HEOR & HTA Fact Sheet
Automate and simplify the management of researchers’ systematic collection of secondary data.